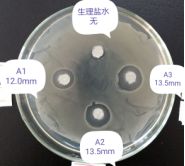
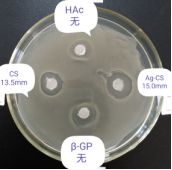

纳米银
关注:4714
参考价格:300/kg
产地:广东中山
CAS NO:7440-22-4
分子式:Ag
纳米银:即纳米级的金属银单质。纳米银微粒,呈球形,直径范围为15-80nm。


X射线衍射
抗菌性研究
抑菌试验(白色念珠菌)


对于白色念珠菌,生理盐水、β-GP、0.1mol/L醋酸都没有抑菌效果,而CS、Ag-CS、Ag-CS/β-GP都有一定的抑菌效果,且随着凝胶溶液的银含量增加,抑菌作用越好。
抑菌试验(金黄色葡萄球菌)

对于金黄色葡萄球菌,生理盐水、β-GP、稀醋酸都没有抑菌效果,而CS、Ag-CS、Ag-CS/β-GP都有一定的抑菌作用,且随着凝胶溶液的银含量增加,抑菌作用越强。
独特功效:1、渗透性强,广谱杀菌且无耐药性; 纳米银微粒具有强渗透性,可迅速渗入皮下2mm杀菌,对耐药病原菌如耐药大肠杆菌、耐药金葡萄球菌、耐药绿脓杆菌、化脓链球菌、耐药肠球菌,厌氧菌等有多面的抗菌活性;对烧烫伤及创伤表面常见的细菌如金黄色葡萄球菌、大肠杆菌、绿脓杆菌、白色念珠菌及其它革兰氏阳性和革兰氏阴性致病菌都有杀菌作用;对沙眼衣原体、引起性传播性疾病的淋球菌也有强大的杀菌作用。 2、促进伤口愈合修复再生 ;纳米银可促进伤口愈合,促进受损细胞的修复与再生,去腐生肌,抗菌消炎改善创伤周围组织的微循环,有效地激活并促进组织细胞的生长,加速伤口的愈合,减少疤痕的生成。3、通过缓释分散载体,延长抗菌时效;4、分散性好,分散均匀稳定,良好的稳定性;5、良好的水溶性;6、良好的生物相容性。
产品发布日期:2021.10.19
安康德美(中山)纳米科技有限公司
